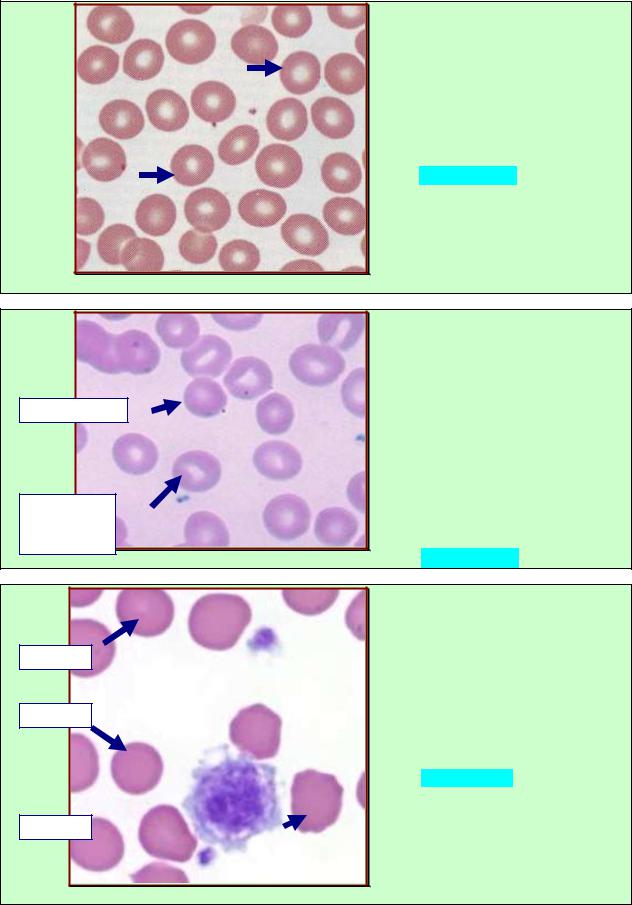
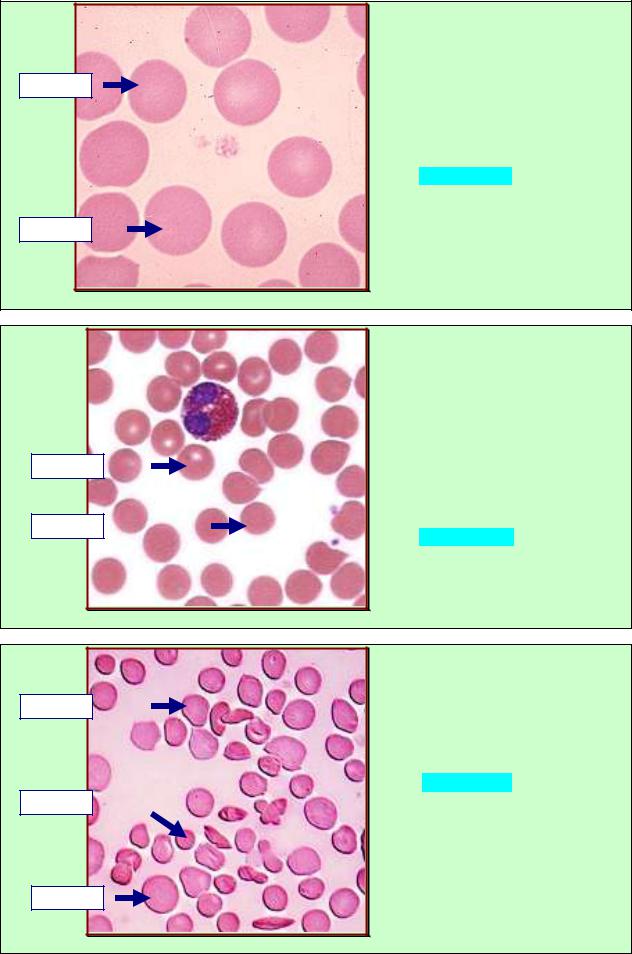

Материал: Obschaya_gistologia_Ch_1__2010

|
|
|
|
55 |
|
|
ЗАДАНИЕ 2.21 |
|
|
||
|
В плазме крови кроме воды, |
||||
|
белков, органических и мине- |
||||
|
ральных соединений, находятся |
||||
Эритроциты |
структуры, |
обозначенные |
на |
||
|
рис.2.21. |
Назовите |
данные |
||
|
структуры. |
|
|
|
|
Лейкоциты |
А. Клетки. |
|
|
|
|
Б. Постклеточные структуры. |
|||||
|
|||||
|
В. Форменные элементы. |
|
|||
|
Г. Производные клеток. |
|
|
||
Эритроциты |
Д. Продукты секреции клеток. |
||||
|
|
|
|
||
|
Рис. 2.21 |
|
|
|
|
|
ЗАДАНИЕ 2.22 |
|
|
В препарате выявили структуру |
|
|
ткани (стрелка), составные |
|
1.90% воды. |
элементы которой обозначены |
|
на рис.2.22. Укажите данную |
||
2.9% органических |
||
веществ (более 200 |
структуру. |
|
видов белки, |
А. Клетки. |
|
углеводы, липиды). |
Б. Постклеточные структуры. |
|
3.1% |
||
В. Форменные элементы. |
||
неорганических |
||
Г. Производные клеток. |
||
веществ. |
||
|
Д. Плазма. |
|
|
Рис.2.22 |
|
ЗАДАНИЕ 2.23 |
|
||
|
В препарате выявили структуру |
|||
|
крови |
(стрелка), |
функции |
|
|
которой |
обозначены |
на |
|
|
рис.2.23. |
Укажите |
данную |
|
|
структуру. |
|
|
|
|
А. Клетки. |
|
|
|
1.Обеспечивает |
Б. Постклеточные структуры. |
|
||
В. Форменные элементы. |
|
|||
высокую |
|
|||
Г. Производные клеток. |
|
|||
подвижность крови. |
|
|||
|
|
|
|
|
2.Трофическая. |
Д. Плазма. |
|
|
|
3.Регуляторная. |
|
|
|
|
4.Защитная. |
|
|
|
|
|
Рис.2.23 |
|
|
|
|
|
56 |
2.4. Эритроциты: строение, функции. Зависимость формы эритроцитов от |
|
|
состояния гемоглобина и плазмолеммы. |
|
|
|
ЗАДАНИЕ 2.24 |
|
У взрослого человека в крови |
||
среди |
форменных |
элементов |
выявляются безъядерные струк- |
||
туры, |
обозначенные стрелками |
|
на рис.2.24. Назовите данные |
||
элементы. |
|
|
А. Ретикулоциты. |
|
|
Б. Эритроциты. |
|
|
В. Тромбоциты. |
|
|
Г. Лейкоциты. |
|
|
Д. Лимфоциты. |
|
|
Рис. 2.24 |
|
|
|
|
ЗАДАНИЕ 2.25 |
||
|
При окрашивании мазка крови |
|||
|
среди |
форменных |
элементов |
|
|
выявили |
многочисленные |
||
Плазмолемма |
структуры, составные компо- |
|||
|
ненты |
которых отмечены на |
||
|
рис.2.25. Назовите данный вид |
|||
|
форменных элементов. |
|||
|
А. Лейкоциты. |
|
|
|
Гомогенная |
Б. Тромбоциты. |
|
||
оксифильная |
В. Ретикулоциты. |
|
||
цитоплазма |
Г. Моноциты. |
|
|
|
Рис. 2.25 |
Д. Эритроциты. |
|
||
|
|
ЗАДАНИЕ 2.26 |
||
|
У здорового взрослого человека |
|||
7.5 мкм |
при |
световой |
микроскопии |
|
мазка |
крови |
выявили |
||
|
||||
|
эритроциты, диаметр которых |
|||
7 мкм |
обозначен на рис.2.26. Назовите |
|||
данный тип эритроцитов. |
||||
|
||||
|
А. Эхиноциты. |
|
||
|
Б. Макроциты. |
|
||
|
В. Нормоциты. |
|
||
|
Г. Микроциты. |
|
||
7.2 мкм |
Д. Стоматоциты. |
|
||
|
|
|
||
|
Рис. 2.26 |
|
|
|
|
|
|
|
|
|
|
57 |
|
|
|
ЗАДАНИЕ 2.27 |
|
|||
|
У |
взрослого |
человека |
при |
|||
|
световой |
микроскопии |
мазка |
||||
9 мкм |
крови |
выявили |
эритроциты, |
||||
|
диаметр которых обозначен на |
||||||
|
рис.2.27. Назовите данный тип |
||||||
|
эритроцитов. |
|
|
|
|||
|
А. Эхиноциты. |
|
|
|
|||
|
Б. Макроциты. |
|
|
|
|||
|
В. Нормоциты. |
|
|
|
|||
|
Г. Микроциты. |
|
|
|
|||
9.2 мкм |
Д. Стоматоциты. |
|
|
|
|||
|
Рис. 2.27 |
|
|
|
|
|
|
|
|
|
ЗАДАНИЕ 2.28 |
|
||||
|
У |
взрослого |
человека |
при |
||||
|
световой |
микроскопии |
мазка |
|||||
|
крови |
выявили |
эритроциты, |
|||||
|
представленные |
на |
рис.2.28. |
|||||
|
Назовите |
|
данный |
|
тип |
|||
6 мкм |
эритроцитов. |
|
|
|
|
|||
|
А. Эхиноциты. |
|
|
|
|
|||
|
Б. Макроциты. |
|
|
|
|
|||
5,7 мкм |
В. Нормоциты. |
|
|
|
|
|||
Г. Микроциты. |
|
|
|
|||||
|
|
|
|
|||||
|
Д. Стоматоциты. |
|
|
|
||||
|
Рис. 2.28 |
|
|
|
|
|
|
|
|
|
|
ЗАДАНИЕ 2.29 |
|
|||
|
У |
взрослого |
человека |
при |
|||
7 мкм |
световой микроскопии в мазке |
||||||
|
крови |
выявили |
эритроциты, |
||||
|
представленные |
|
на |
рис.2.29. |
|||
|
Назовите данное явление. |
|
|||||
|
А. Анизоцитоз. |
|
|
|
|
||
5,7 мкм |
Б. Макроцитоз. |
|
|
|
|
||
|
В. Пойкилоцитоз. |
|
|
|
|||
|
Г. Микроцитоз. |
|
|
|
|
||
|
Д. Сфероцитоз. |
|
|
|
|
||
9 мкм |
|
|
|
|
|
|
|
|
Рис. 2.29 |
|
|
|
|
|
|

|
58 |
|
|
ЗАДАНИЕ 2.30 |
|
|
При электронной микроскопии |
|
Плазмолемма |
форменного элемента крови в |
|
|
его составе выявили структур- |
|
|
ные компоненты, обозначенные |
|
|
на рис.2.30. Назовите данный |
|
Цитоплазма с |
элемент. |
|
А. Лейкоцит. |
||
включениями |
||
гемоглобина |
Б. Тромбоцит. |
|
|
В. Ретикулоцит. |
|
|
Г. Эритроцит. |
|
|
Д. Моноцит. |
|
|
Рис. 2.30 |
ЗАДАНИЕ 2.31 |
|
|
У здорового взрослого человека |
||
при сканирующей электронной |
||
микроскопии |
выявили |
много |
эритроцитов |
характерной |
|
формы, обозначенных стрел- |
||
ками на рис.2.31. Назовите |
||
данный тип эритроцитов. |
|
|
А. Дискоциты. |
|
|
Б. Планоциты. |
|
|
В. Сфероциты. |
|
|
Г. Эхиноциты. |
|
|
Д. Стоматоциты. |
|
|
Рис. 2.31 |
|
|
|
|
ЗАДАНИЕ 2.32 |
|
|
|
У |
взрослого |
человека |
при |
||
сканирующей |
электронной |
||||
микроскопии |
выявили |
эритро- |
|||
циты |
характерной |
формы, |
|||
обозначенные |
стрелками |
на |
|||
рис.2.32. Назовите данный тип |
|||||
эритроцитов. |
|
|
|
||
А. Дискоциты. |
|
|
|
||
Б. Планоциты. |
|
|
|
||
В. Сфероциты. |
|
|
|||
Г. Эхиноциты. |
|
|
|
||
Д. Стоматоциты. |
|
|
|||
Рис 2.32 |
|
|
|
|
|

|
|
|
|
|
|
|
|
|
59 |
|
|
|
|
ЗАДАНИЕ 2.33 |
|
||||
Светлый центр в |
|
У |
взрослого человека в мазке |
||||||
|
крови |
выявили |
эритроциты |
||||||
виде изогнутой |
|
||||||||
|
(стрелки) |
с |
|
характерным |
|||||
палочки |
|
|
|||||||
|
|
|
|
|
|
|
|
|
|
|
|
признаком, |
обозначенным |
на |
|||||
|
|
рис.2.33. Назовите данный тип |
|||||||
|
|
эритроцитов. |
|
|
|
|
|||
|
|
А. Дискоциты. |
|
|
|
|
|||
|
|
Б. Планоциты. |
|
|
|
|
|||
|
|
В. Сфероциты. |
|
|
|
|
|||
|
|
Г. Эхиноциты. |
|
|
|
|
|||
|
|
Д. Стоматоциты. |
|
|
|
||||
|
Рис. 2.33 |
|
|
|
|
|
|
|
|
|
|
|
|
ЗАДАНИЕ 2.34 |
|
||||
|
|
У |
взрослого |
человека |
при |
||||
|
|
электронной |
|
микроскопии |
|||||
Серповидноклеточная |
|
среди |
эритроцитов |
выявили |
|||||
форма |
|
элементы, |
представленные |
на |
|||||
|
|
||||||||
|
|
рис.2.34. |
Назовите |
данное |
|||||
|
|
явление. |
|
|
|
|
|
||
|
|
А. Анизоцитоз. |
|
|
|
|
|||
|
|
Б. Макроцитоз. |
|
|
|
|
|||
|
|
В. Пойкилоцитоз. |
|
|
|
||||
Дискоцит |
|
Г. Микроцитоз. |
|
|
|
|
|||
|
Рис. 2.34 |
Д. Сфероцитоз. |
|
|
|
|
|||
|
|
|
|
|
|
|
|
|
|
|
ЗАДАНИЕ 2.35 |
|
Гликокаликс |
На схеме строения эритроцита |
|
выявили слои, обозначенные на |
||
|
||
|
рис.2.35. Какую структуру они |
|
|
формируют? |
|
Клеточная |
А. Систему открытых каналов. |
|
мембрана |
Б. Плазмолемму. |
|
|
||
|
В. Ядерную оболочку. |
|
Подмемб- |
Г. Комплекс Гольджи. |
|
ранный |
Д. Систему эндосом. |
|
слой |
|
|
|
Рис.2.35 |